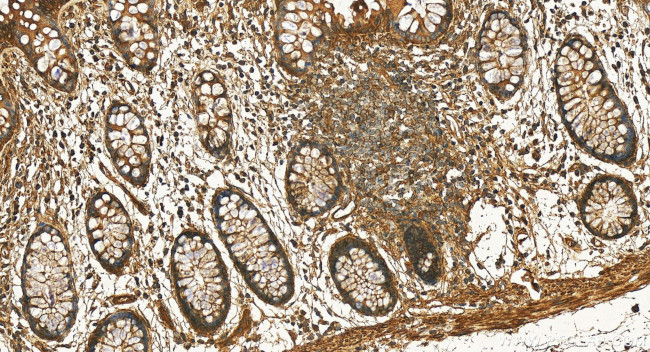
FAR2 Antibody in Immunohistochemistry (Paraffin) (IHC (P))

Search
Proteintech
FAR2 Polyclonal Antibody
{{$productOrderCtrl.translations['antibody.pdp.commerceCard.promotion.promotions']}}
{{$productOrderCtrl.translations['antibody.pdp.commerceCard.promotion.viewpromo']}}
{{$productOrderCtrl.translations['antibody.pdp.commerceCard.promotion.promocode']}}: {{promo.promoCode}} {{promo.promoTitle}} {{promo.promoDescription}}. {{$productOrderCtrl.translations['antibody.pdp.commerceCard.promotion.learnmore']}}
产品信息
27717-1-AP
种属反应
宿主/亚型
分类
类型
抗原
偶联物
形式
浓度
规格
纯化类型
保存液
内含物
保存条件
运输条件
产品详细信息
Sequence of this protein is as follows: LQQRVFQILD SKLFEKVKEV CPNVHEKIRA IYADLNQNDF AISKEDMQEL LSC
靶标信息
This gene belongs to the short chain dehydrogenase/reductase superfamily. It encodes a reductase enzyme involved in the first step of wax biosynthesis wherein fatty acids are converted to fatty alcohols. The encoded peroxisomal protein utilizes saturated fatty acids of 16 or 18 carbons as preferred substrates. Alternatively spliced transcript variants have been observed for this gene. Related pseudogenes have been identified on chromosomes 2, 14 and 22.
仅用于科研。不用于诊断过程。未经明确授权不得转售。
篇参考文献 (0)
生物信息学
蛋白别名: epididymis secretory protein Li 81; FAR2; fatty acyl CoA reductase 2; Fatty acyl-CoA reductase 2; male sterility domain containing 1; Male sterility domain-containing protein 1; short chain dehydrogenase/reductase family 10E, member 2; unnamed protein product
基因别名: A230046P18; AW048109; BC055759; FAR2; HEL-S-81; MLSTD1; RGD1565966; SDR10E2
UniProt ID: (Human) Q96K12, (Mouse) Q7TNT2
Entrez Gene ID: (Human) 55711, (Rat) 500368, (Mouse) 330450